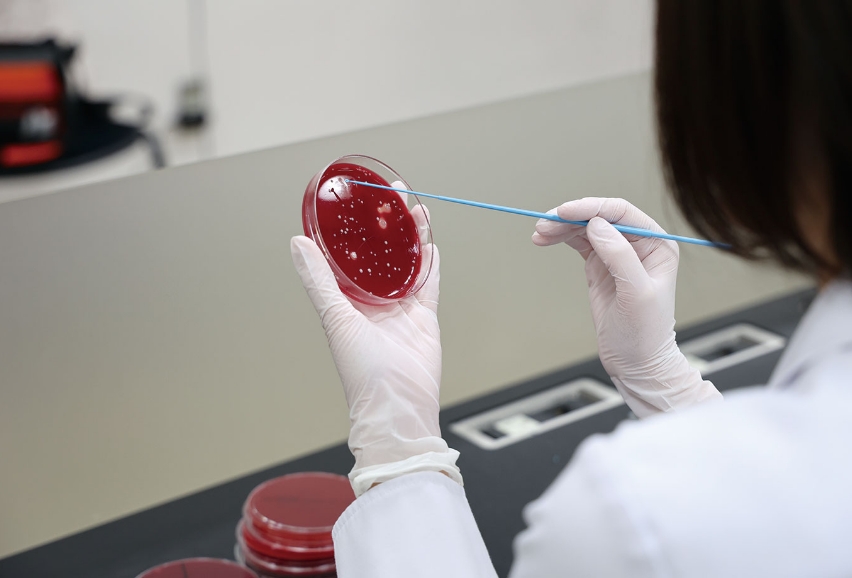

正しい衛生知識を提供するための
生活に隠れた身近な微生物の研究とは?
臨床技術学科/助教/涌井 杏奈
Department of Clinical Engineering and Medical Technology/Anna Wakui

日常生活に馴染みの深い“もの”に潜在する微生物の量および種類の研究
大学時代は口腔内の細菌、現在は「身近な微生物」を研究テーマに。
疾患研究とは異なる別のアプローチで人々の健康を支えたい
私は大学時代、医学部保健学科で臨床検査技師を目指して学びました。修士課程では約1ヶ月の間、ボストンへの研究留学や国際学会発表など諸々の経験するなど、視野が広がる貴重な経験を積むことができました。
修士課程修了後は、博士課程に進学し、大学病院で勤務しながら大学院を修了(博士号を取得)し、研究に専念する道を選択しました。大学時代から継続して、「身近な微生物」をテーマに研究を進めています。私たち、ヒトの身体には「常在菌」と呼ばれる微生物が生息していることが明らかになっており、その数は約10兆〜100兆個に及ぶと言われています。常在菌は主に口腔、皮膚、消化管に生息していますが、私たちの生活に欠かせない“もの”にはどれくらいの微生物が存在しており、それらがどのように私たちの生活や健康に影響を与えているのでしょうか??これが、私の研究のテーマです。
人々の健康の手助けになる、まだ解明されていないことを科学的に検証
私たちは日常的に消毒や手洗いで感染を防ごうとしていますが、その根拠が科学的に解明されていない場合も少なくないのです。医学の研究では疾患を対象にすることが多いですが、日常生活に関わる微生物についての研究はまだ多くはないからです。私の研究は、こうした身近な生活に潜む微生物の実態を解明し、私たちの健康を見直す手助けになることを目指しています。
スマートフォンの画面や不織布マスクに潜む細菌について研究。適切な消毒や利用の方法を提案し、健やかな暮らしとQOL向上へ
最近、行った研究で、スマートフォン画面には特別な消毒をしなくても細菌は160個程度しかなく、手指に存在する約1,000個よりも大幅に少ないことが分かりました。また、不織布マスクには半日程度の着用で約2万個の微生物が付着することが明らかになりました。一見多く感じられますが、私たちの身体には10兆〜100兆個もの微生物がいるため、それに比べるとかなり少ない量といえます。さらに付着した微生物は、どちらも皮膚にいる細菌と同じ種類であることから、過度な心配はいらないのかもしれません。とすれば、災害時など、不織布マスクを再利用せざるを得ない状況でも、安全な使用方法を考案・提案できる可能性があると考えています。現在は、さらに発展させ、抗菌機能付きマスクや消毒スプレーの効果も検証中です。メディアや広告では、微生物すべてが悪影響を及ぼすかのように扱われることがありますが、微生物の中には皮膚常在菌のように私たちを守ってくれる存在のものもあります。身近な細菌をテーマとして研究することで、適切な対処の方法(例えば消毒の頻度や方法など)を提案し、人々の健康と生活の質(QOL)向上に役立てたいと考えています。